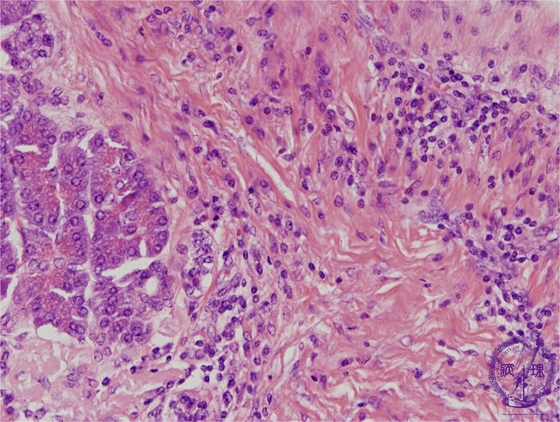

- 11.Gallbladder, Pancreas
- (5)Chronic pancreatitis
Microscopic findings(HE stain, high power) :Fibrosis of the remaining pancreatic parenchyma and interlobular spaces.Fibrosis involves mainly the perilobular area and spares the intra-acinar spaces.The inflammatory cell infiltrate comprises mainly lymphocytes.
Click the image to see the enlarged image.










